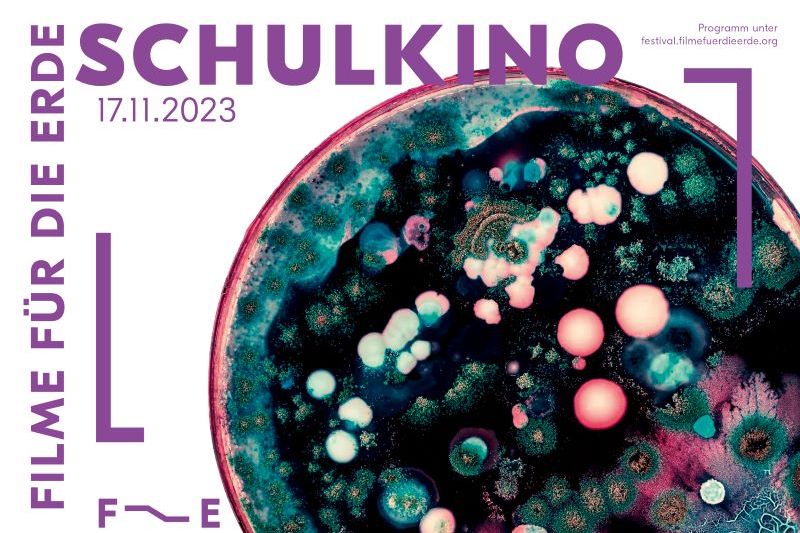

Dabei werden in der Aula der Schule Schönenwegen und dem KBZ Umweltdokus gezeigt, die Wissen vermitteln, sensibilisieren, Bewusstsein für die Vielfalt unserer Erde schaffen und gleichzeitig mit einzigartigen Bildern begeistern. Die Filme eignen sich für jede Altersgruppe - von der Unter- bis hin zur Oberstufe.
Hier sehen Sie das Schulkinoprogramm auf einen Blick.
Freitag, 17. November 2023, 09.00 - 10.00 Uhr
Winter am Alpenrand
für Unter- und Mittelstufen, Sprache: Deutsch
Freitag, 17. November 2023, 10.30 - 11.30 Uhr
Die Geschichte vom Orangeroten Heufalter
für Unter- und Mittelstufen, Sprache: Deutsch
Freitag, 17. November 2023, 12.00 - 13.00 Uhr
SOKO Gartenschläfer
Für Mittel- und Oberstufen, Sprache: Deutsch
Freitag, 17. November 2023, 14.00 - 15.00 Uhr
Eine neue Welt
für Oberstufen, Sprache: Deutsch
Das Angebot ist für Schüler:innen kostenlos, lediglich für die Lehrpersonen wird eine einmalige Administrationsgebühr von CHF 20.00 erhoben.
Alle Informationen zum Schulkino, zu den Filmen und zu den Standorten finden Sie hier:
https://festival.filmefuerdieerde.org/schulkino/
Die spezifischen Informationen für St. Gallen sind hier ersichtlich:
https://festival.filmefuerdieerdeorg/standort/st-gallen-schulkino/